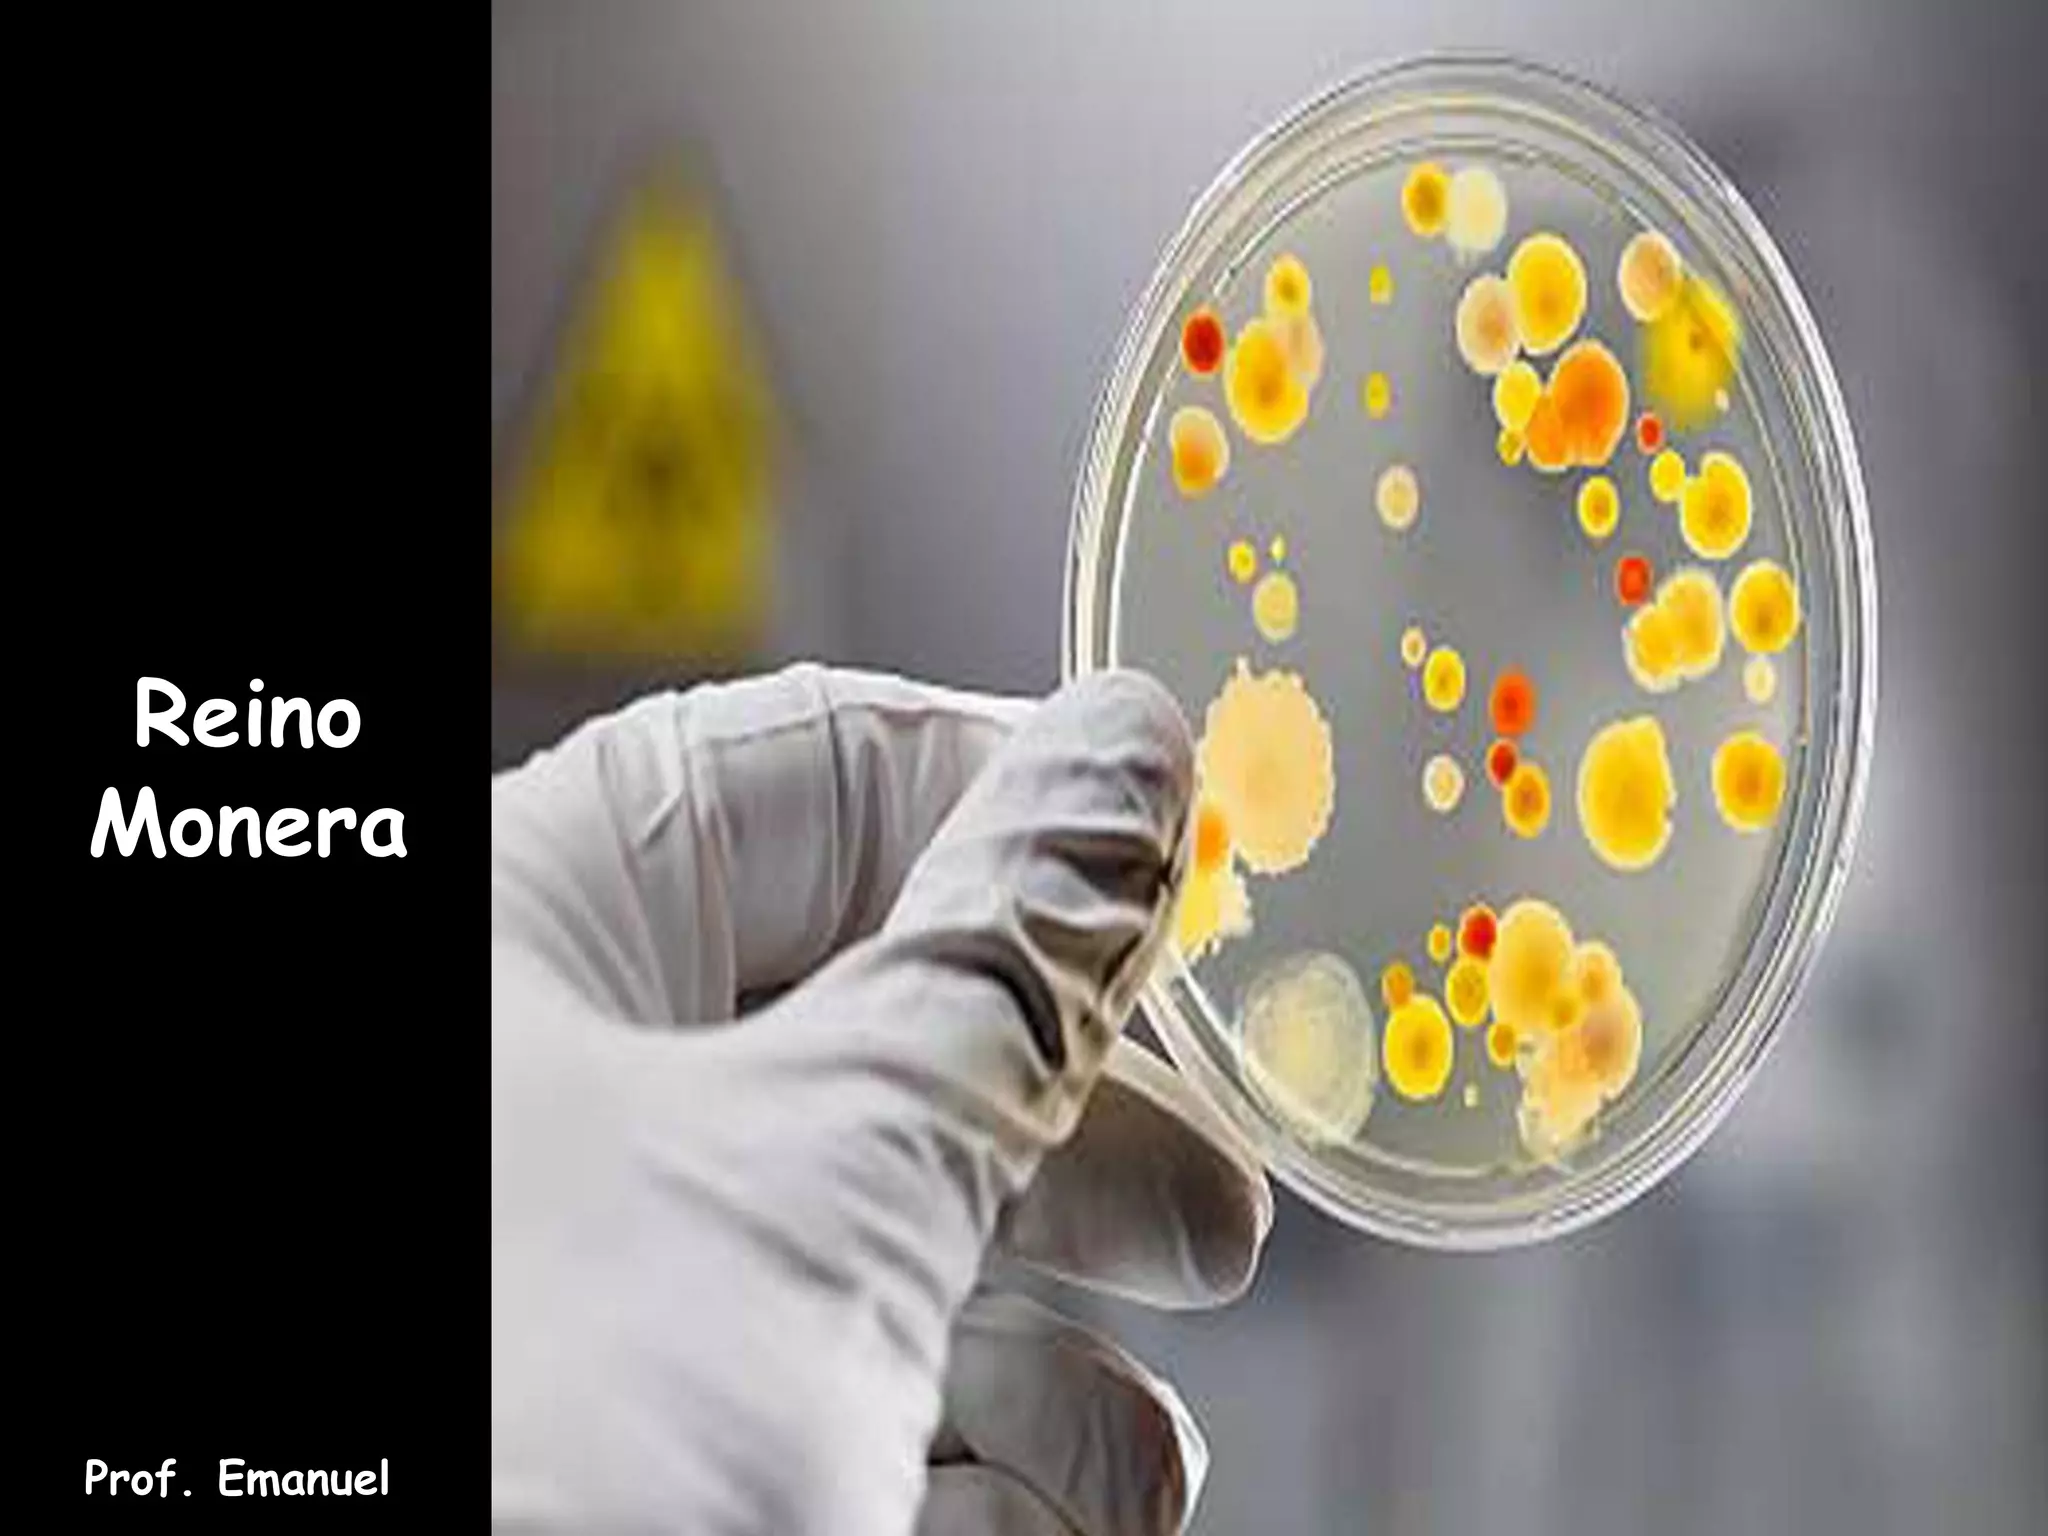

O documento resume as principais características dos reinos Monera e Protista. Apresenta informações sobre a morfologia, estrutura e reprodução de bactérias, assim como sobre cianobactérias, micoplasmas, clamídias e rickettsias. Explica também conceitos como mutação, resistência a antibióticos e biofilmes bacterianos.